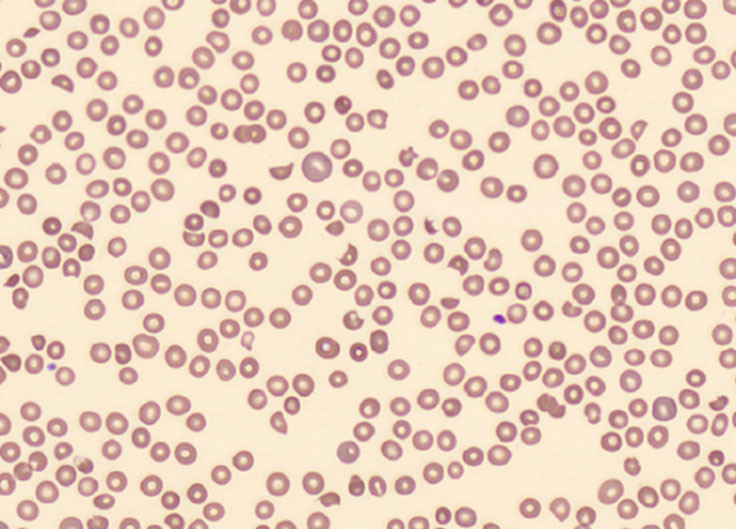
Figur 1 Blodutstryk fra dag 4 viser rikelig med schistocytter, opptil 4&nbsp;%.

En mann i 50-årene ble innlagt med anemi, trombocytopeni og akutt nyresvikt. Vi beskriver her utredning og behandling av de vanligste differensialdiagnosene, og belyser viktigheten av god anamnese og bred utredning på veien mot rett diagnose.
En tidligere frisk mann ble innlagt på lokalsykehus med makroskopisk hematuri. To dager tidligere hadde legevakt forskrevet tabletter med pivmecillinam mot mistenkt urinveisinfeksjon grunnet makroskopisk hematuri – uten behandlingseffekt. Diuresen var god. I akuttmottaket var han afebril med blodtrykk på 147/94 mm Hg. Han hadde ingen nevrologiske utfall ved undersøkelse. Han hadde petekkier på brystkasse og legger, ødemer i underekstremitetene og ikteriske sclera. Blodprøver viste C-reaktivt protein (CRP) på 23 mg/L (referanseområde < 5), hemoglobin (Hb) 12,0 g/dL (13,4–17,0), leukocyttall 7,6 ∙ 109/L (3,5–10,0), trombocyttall 9 ∙ 109/L (145–390), internasjonal normalisert ratio (INR) 1,1 (0,9–1,2), kalium 4,8 mmol/L (3,5–4,4), alanin aminotransferase (ALAT) 26 U/L (10–70), aspartat aminotransferase (ASAT) 78 U/L (15–45), kreatinin 255 umol/L (60–105), estimert glomerulær filtrasjonsrate (eGFR) 29 ml/min/1,73 m2 (> 60), total bilirubin 79 umol/L (5–25), laktatdehydrogenase (LD) 2142 U/L (105–205) og supprimert haptoglobin < 0,1 g/L (0,4–2,1). Blodutstryk og direkte antiglobulin test (DAT) ble ikke utført ved innkomst. Karbamid ble ikke tatt, og antinukleære antistoffer (ANA), antistoff mot nøytrofilt cytoplasma-antigen (ANCA) eller antistoffer mot nyrenes glomerulære basalmembran (anti-GBM) ble heller ikke målt. Urinstiks ble ikke gjentatt, men fra legevakt ble den angitt som positiv for både blod (+3), protein (+3), leukocytter (+2) og nitritt.
Blodprøvene viste hemolytisk anemi, med høyt LD-nivå frigitt fra ødelagte erytrocytter, høyt bilirubinnivå fra nedbrutt hemoglobin, samt lavt haptoglobinnivå grunnet forbruk som bæremolekyl for fritt hemoglobin. Med tilleggsfunn av trombocytopeni og akutt nyresvikt ble det mistenkt trombotisk mikroangiopati (TMA). Regionsykehuset ble kontaktet for å ta over diagnostikk og videre forløp.
Ved ankomst til regionsykehuset var pasienten i god allmenntilstand. Det ble utført direkte antiglobulintest (DAT), som var negativ. Blodutstryk viste 5 % schistocytter (fragmenterte erytrocytter).
Hemolytisk anemi kan inndeles etter DAT-status. Antistoffer på erytrocyttenes overflate gir en positiv test og indikerer immunmediert hemolyse. Negativ test taler for mekanisk ødeleggelse av erytrocyttene (1). DAT-negativ (mekanisk) hemolyse med normale trombocytter er vanligvis ufarlig, og kan for eksempel skyldes kunstig hjerteklaff. Ved samtidig trombocytopeni må man imidlertid overveie en rekke alvorlige diagnoser, som samlet betegnes som trombotisk mikroangiopati. Her foregår trombosering i mikrosirkulasjonen med forbruk av blodplater, som gir trombocytopeni. Erytrocyttene fragmenteres når de passerer mikrotrombene og gir mekanisk hemolyse. Erytrocytter med synlige skader kalles schistocytter (2). Funn av mer enn 1 % schistocytter i blodutstryk er signifikant (figur 1). Trombotisk mikroangiopati kan raskt gi organdysfunksjon, avhengig av hvor mikrotrombene setter seg.
Med et klinisk bilde bestående av DAT-negativ hemolytisk anemi, trombocytopeni og organdysfunksjon (nyreskade, mage- og tarmsymptomer, nevrologiske utfall) bør man kontakte nefrolog og/eller hematolog. Det er tre primære syndromer man bør tenke på: trombotisk trombocytopenisk purpura (TTP); shigatoksin-indusert hemolytisk-uremisk syndrom (ST-HUS) og komplementmediert trombotisk mikroangiopati (komplementmediert TMA, tidligere omtalt som atypisk hemolytisk-uremisk syndrom) (3).
Flere systemiske tilstander kan også gi DAT-negativ hemolyse og trombocytopeni, som malign hypertensjon, svangerskapskomplikasjoner og sepsis (tabell 1). Koagulasjonsprøver kan være avklarende. Trombotisk mikroangiopati har fibrinfrie tromber, med normalt fibrinogennivå og tilnærmet normalt nivå av D-dimer. Ved sepsis med disseminert intravaskulær koagulasjon sees nedsatt nivå av fibrinogen og forhøyet nivå av D-dimer, grunnet fibrinholdige mikrotromber (2, 3).
Tabell 1
Oversikt over primære symptomer på trombotisk mikroangiopati (TMA) og noen viktige systemiske tilstander med liknende presentasjon (2, 3, 12).
| Primære TMA-syndromer (sjeldne)1 | Kliniske funn | Vesentlige laboratoriefunn | Behandling |
|---|---|---|---|
| TTP (ervervet) | Multiorganaffeksjon | ADAMTS13 < 10 % | Terapeutisk plasmaferese |
| ST-HUS | 5–7 dager etter gastrointestinal infeksjon | Shigatoksin og enterohemoragisk E. coli i avføringsprøve | Støttebehandling |
| Komplementmediert TMA | Ofte hypertensjon | Komplementaktivering | Antikomplement behandling (ekulizumab) |
| Andre Systemiske tilstander (hyppige) 2 | |||
| Alvorlig hypertensjon | Blodtrykk > 220/100 mm Hg | Mikroalbuminuri/ proteinuri | Blodtrykkskontroll |
| Sepsis med DIC3 | Høy feber | Høy CRP og D-dimer | Antibiotika Støttebehandling |
| Alvorlig preeklampsi / HELLP | Blodtrykk > 140/90 mm Hg | Proteinuri (> 0,3 g/24t) | Blodtrykkskontroll |
1Listen er ikke utfyllende, det kan i tillegg nevnes hereditær TTP, metabolismemediert TMA, koagulasjonsmediert TMA og medikamentmediert TMA.
2Listen er ikke utfyllende. Malignitet, autoimmune sykdommer, pankreatitt, organ- eller hematopoetisk stamcelletransplantasjon kan alle gi TMA-liknende presentasjon.
3DIC kan også forekomme ved malignitet, traumer, pankreatitt og obstetriske komplikasjoner.
Pasienten hadde ikke hatt diaré eller kliniske funn som tydet på alvorlig infeksjon. Han var våken og klar. Det ble sikret blodkulturer, nasofarynks- og urinprøver. Avføringsprøver ble ikke tatt. Kreatinin var steget fra 255 til 292 umol/L (eGFR 29–21), og karbamid ble målt til 20,6 mmol/L (3,5–8,1). Urinmikroskopi viste rikelig med korte, kornede sylindre og en del normalt utseende erytrocytter. På grunn av uttalt trombocytopeni mistenkte man trombotisk trombocytopenisk purpura, og det ble raskt startet plasmautskiftning og prednisolon 1 mg/kg peroralt. Før oppstart sikret man blodprøver for utvidet hematologisk diagnostikk, inkludert komplementanalyser.
Trombotisk trombocytopenisk purpura er en livstruende hematologisk tilstand, ofte med symptomer fra sentralnervesystemet, og den krever øyeblikkelig behandling med plasmautskiftning. Tilstanden skyldes alvorlig mangel på enzymet ADAMTS13 (A Disintegrin And Metalloprotease with a ThromboSpondin type 1 motif, member 13). Dette enzymet spalter ultralange kjeder av von Willebrands faktor i blodbanen og har en viktig antitrombotisk reguleringsfunksjon. Uten spaltingen vil de ultralange kjedene binde og aktivere blodplater og danne intravaskulære mikrotromber. Redusert ADAMTS13-aktivitet i plasma er patognomonisk for tilstanden. De fleste tilfeller er ervervet, hvor autoantistoffer bryter ned ADAMTS13-enzymet (3). Plasmautskiftning fjerner både de skadelige kjedene og autoantistoffene, samtidig som det tilføres ADAMTS13-enzym. Trombocytt-transfusjon bør unngås, da det kan øke tromboseringstendensen. Immundempende behandling med steroider og eventuelt rituksimab kan gis for å hemme pasientens autoantistoffproduksjon (2).
På dag 3 hadde trombocyttallet steget fra 9 til 22 ∙ 109/L. Det ble utført ny plasmautskiftning og startet hemodialyse grunnet nyresvikten. Pasienten var i god allmenntilstand, uten nevrologiske symptomer, og ble overflyttet til lokalsykehus. Blodutstryk viste vedvarende hemolyse med fragmenterte blodceller. Behandling ble kontinuert med daglig hemodialyse, plasmautskiftning og peroral prednisolon 40 mg x 2.
Resultatet fra ADAMTS13-undersøkelsen forelå på dag 4, hvor normal aktivitet ble påvist. Trombotisk trombocytopenisk purpura (TTP) var dermed utelukket, og andre differensialdiagnoser måtte vurderes.
På dag 5 hadde trombocyttallet steget til 35 ∙ 109/L. Kreatininnivået var fortsatt høyt på 450 μmol/L, hvorpå ny hemodialyse og plasmautskiftning ble utført. Supplerende analyser av regulatoriske proteiner i komplementsystemet forelå ennå ikke. Utredningen ga ikke mistanke om andre systemiske tilstander. Man avsto fra nyrebiopsi, da biopsi ikke kan skille mellom de ulike typene trombotisk mikroangiopati, samt på grunn av økt blødningsrisiko. Det ble aldri utført radiologisk undersøkelse av nyrene.
Etter diskusjon med nefrologer og hematologer på regionsykehuset, ble komplementmediert trombotisk mikroangiopati vurdert som sannsynlig diagnose. Ved denne tilstanden kan tidlig behandling med komplementhemmeren ekulizumab begrense irreversibel nyreskade, og det ble besluttet oppstart med dette. Da ekulizumab ikke umiddelbart var tilgjengelig, kontinuerte man behandling med plasmautskiftning.
Komplementsystemet er en del av det medfødte immunforsvaret og aktiveres via ulike veier (2, 4, 5). Den ene aktiveringsveien er kontinuerlig selvaktiverende og er avhengig av regulatoriske proteiner for å holdes i sjakk (6). Mutasjoner eller ervervede forstyrrelser kan gjøre disse regulatoriske proteinene dysfunksjonelle, med ledsagende overaktivering av systemet, som kan utløse komplementmediert trombotisk mikroangiopati. Utløsende faktorer kan være infeksjoner eller annen sykdom. Plasmautskiftning ble tidligere brukt til behandling, men siden 2011 har ekulizumab overtatt som førstelinjebehandling. Ekulizumab er et monoklonalt antistoff som hemmer dannelsen av det siste komplekset i komplementkaskaden, og dermed stopper komplementaktiveringen på dette nivået. Behandlingen gjør pasienten mer utsatt for infeksjon med kapselkledde mikrober, som for eksempel meningokokker, og det gis derfor beskyttende vaksine og profylaktisk behandling mot slike infeksjoner (6, 7). Ekulizumab er kostbart og ikke alltid tilgjengelig ved lokalsykehus.
Ekulizumab ble tilgjengelig og administrert tidlig på dag 7. Samme dag fortalte pasienten at han 7–10 dager før innleggelsen blant annet hadde spist sauekjøtt. Han hadde hatt lette magesmerter i dagene før innleggelse, men ikke diaré. Det ble tatt avføringsprøver, hvorpå man dagen etter påviste DNA fra enterohemoragisk Escherichia coli (EHEC), med gen for Shigatoksin 2f. Diagnosen var da overveiende sannsynlig shigatoksin-indusert hemolytisk-uremisk syndrom (ST-HUS), tross minimalt med symptomer i forkant. Behandlingen med plasmautskiftning og Ekulizumab ble avsluttet, og prednisolon faset ut. Støttebehandlingen med hemodialyse ble kontinuert.
Noen dager senere forelå fullstendig svar på komplementanalyser, som alle var normale. Sannsynligheten for samtidig komplementmediert trombotisk mikroangiopati var lav, og ble ansett for utelukket. To uker senere ble DNA-funnet av enterohemoragisk E. coli bekreftet ved dyrkning. Påvist gen for Shigatoksin 2f ble også bekreftet av Folkehelseinstituttet. Inkubasjonstiden passet godt med inntaket av sauekjøtt.
Shigatoksin-indusert hemolytisk-uremisk syndrom (ST-HUS) er den vanligste formen for trombotisk mikroangiopati og skyldes infeksjon med shigatoksin-produserende enterohemoragisk E. coli (EHEC) eller Shigella dysenteriae (2). Naturlige reservoarer for mikrobene finnes i tarmen hos storfe og sau. Smitte skjer ved inntak av ufullstendig tilberedt kjøtt, urent vann eller kontakt med infiserte dyr. Shigatoksinet påvirker først tarmslimhinnen og kan deretter affisere nyrene. Etter median inkubasjonstid på fire dager utvikles vanligvis magesmerter og vandig diaré, etterfulgt av akutt nyresvikt. Kvalme og feber er mindre hyppig. Opptil en tredjedel av pasientene utvikler kolitt med blodig diaré (8). I nyrene bindes shigatoksinet i glomeruli og samlerørsystemet. Dette medfører skade, inflammasjon og mikrovaskulær trombose (3). Den mekaniske hemolysen skjer når erytrocyttene passerer gjennom tromboserte kar i glomeruli (9). Graden av nyresvikt varierer fra mild til alvorlig.
Pasientens nyrefunksjon ble gradvis bedre, parallelt med avtakende hemolyse og stigende trombocyttall. Hemodialyse ble avsluttet etter tre uker. Blodoverføringer ble gitt til dag 17. Han ble utskrevet dag 26 med oppfølging på nefrologisk poliklinikk. Nyrefunksjonen normaliserte seg i løpet av seks måneder.
Diskusjon
Pasientens diagnose var shigatoksin-indusert hemolytisk-uremisk syndrom (ST-HUS). De fleste smittetilfeller er selvbegrensende og kun 10–20 % vil utvikle hemolytisk-uremisk syndrom (8). Tilstanden forekommer hyppigst hos barn. Det finnes ingen spesifikk behandling. Opptil 40–50 % behøver nyreerstattende behandling, og 70–80 % trenger blodtransfusjon (8). Tidlig liberal væskebehandling anbefales og er assosiert med redusert risiko for komplikasjoner. Nyresvikten behandles etter gjeldende retningslinjer med støttende medikamenter og hemodialyse (3, 8). Hypertensjon kan gi trombotiske lesjoner og bør behandles (8). Antibiotika og antidiaretikum anbefales ikke. Evidensgrunnlaget for plasmautskiftning hos voksne med alvorlig nyresvikt og affeksjon av sentralnervesystemet er sparsomt (9, 10). Resultatene ved bruk av ekulizumab er sprikende. En studie fra 2023 viste ingen sikker effekt av ekulizumab i akuttfasen, men indikerte reduksjon i nyresekveler etter ett år (11). Forsøk på å utvikle medikamenter som binder shigatoksin, har vært mislykkede. Med god støttebehandling kommer de fleste seg innen noen uker, men opp mot 30 % får langvarig redusert nyrefunksjon (10).
Kasuistikken illustrerer de vanskelige diagnostiske overveielsene ved trombotisk mikroangiopati (DAT-negativ hemolyse og trombocytopeni). Trombotisk trombocytopenisk purpura er den mest alvorlige tilstanden og må behandles med umiddelbar plasmautskiftning, men man ender ofte opp med en annen diagnose. Vår pasient hadde shigatoksin-indusert hemolytisk-uremisk syndrom med alvorlig akutt nyresvikt, og ble til slutt helt frisk med støttebehandling.
En hemolytisk anemi som er DAT-negativ (mekanisk og ikke immunmediert), og som oppstår samtidig med trombocytopeni, gir mistanke om trombotisk mikroangiopati, uavhengig av nyrefunksjon. En bred diagnostisk tilnærming er viktig, da både primære syndromer og systemiske tilstander kan gi et liknende klinisk bilde. Primære syndromer med trombotisk mikroangiopati er sjeldne, insidensen av ervervet trombotisk trombocytopenisk purpura er for eksempel 2,9 per million (3). Tabell 1 gir en oversikt over de viktigste primære syndromene og noen systemiske tilstander med liknende klinisk presentasjon.
Symptomene avhenger av lokalisasjonen for mikrotromboseringen. Ved trombotisk trombocytopenisk purpura ses ofte nevrologiske symptomer av ulik grad, som hjerneslag, krampeanfall og sensibilitetsutfall. Nyresvikt er lite fremtredende, tross dokumenterte mikrotromber i nyrer. Nyresvikt er mer uttalt ved shigatoksin-indusert hemolytisk-uremisk syndrom og komplementmediert trombotisk mikroangiopati. Det finnes ingen diagnostiske urinmikroskopifunn typisk for trombotiske mikroangiopatier.
Shigatoksin-indusert hemolytisk-uremisk syndrom er vanligvis forutgått av magesmerter og blodig diaré, men ikke obligat. Nevrologiske symptomer ses også hos 25 % av disse pasientene. Infeksjon og diaré kan også forutgå debut av komplementmediert trombotisk mikroangiopati, og gjør det vanskelig å skille fra shigatoksin-indusert sykdom (2, 12). Den kliniske presentasjonsformen overlapper således i betydelig grad mellom tilstandene.
Dette betyr i praksis at dersom mistanke om trombotisk trombocytopenisk purpura er til stede, skal terapeutisk plasmautskiftning raskt igangsettes i påvente av endelig diagnostikk, da tilstanden ubehandlet har mortalitet på over 90 % (2). All relevant diagnostikk bør tas før plasmautskiftningen startes (figur 2). Fravær av magesmerter og diaré hos vår pasient bidro trolig til at avføringsprøver ble tatt sent i forløpet.

Normalt nivå av ADAMTS13-aktivitet utelukker trombotisk trombocytopenisk purpura (TTP). Man må tidlig vurdere sannsynlighet for komplementmediert trombotisk mikroangiopati, der komplementhemmende behandling med ekulizumab anbefales innen 1–2 døgn for å forhindre irreversibel nyreskade. Komplementanalyser er tidkrevende, og vil sjelden være besvart i tide. Ekulizumab er kostbart, og med potensial for alvorlige bivirkninger, men ble gitt til vår pasient grunnet alvorlig dialysekrevende nyresvikt før endelig diagnose ble avklart med avføringsprøve. Dersom avføringsprøven hadde blitt tatt tidligere, kunne behandlingen med ekulizumab vært unngått.
Konklusjon
Pasienten hadde shigatoksin-indusert hemolytisk-uremisk syndrom. Selv om større utbrudd har fått mest omtale, er 75 % av tilfellene sporadiske, slik som i dette tilfellet. Blodig diaré er ikke alltid til stede, og 20–30 % opplever ikke dette symptomet. Sammenfattet viser kasuistikken problemstillingene ved håndtering av trombotisk mikroangiopati, hvor vi ikke må glemme betydningen av en grundig anamnese og enkle undersøkelser.
Pasienten har gitt samtykke til at artikkelen blir publisert.
Artikkelen er fagfellevurdert.
- 1.
Zantek ND, Koepsell SA, Tharp DR et al. The direct antiglobulin test: a critical step in the evaluation of hemolysis. Am J Hematol 2012; 87: 707–9. [PubMed][CrossRef]
- 2.
Thompson GL, Kavanagh D. Diagnosis and treatment of thrombotic microangiopathy. Int J Lab Hematol 2022; 44 (Suppl 1): 101–13. [PubMed][CrossRef]
- 3.
George JN, Nester CM. Syndromes of thrombotic microangiopathy. N Engl J Med 2014; 371: 1847–8. [PubMed][CrossRef]
- 4.
Nester CM, Feldman DL, Burwick R et al. An expert discussion on the atypical hemolytic uremic syndrome nomenclature-identifying a road map to precision: a report of a National Kidney Foundation Working Group. Kidney Int 2024; 106: 326–36. [PubMed][CrossRef]
- 5.
Goodship TH, Cook HT, Fakhouri F et al. Atypical hemolytic uremic syndrome and C3 glomerulopathy: conclusions from a "Kidney Disease: Improving Global Outcomes" (KDIGO) Controversies Conference. Kidney Int 2017; 91: 539–51. [PubMed][CrossRef]
- 6.
Lappegård KT, Bjerre A, Tjønnfjord GE et al. Terapautisk komplementhemming – fra eksperimentell til klinisk medisin. Tidsskr Nor Legeforen 2015; 135: 1745–9. [PubMed][CrossRef]
- 7.
Legendre CM, Licht C, Muus P et al. Terminal complement inhibitor eculizumab in atypical hemolytic-uremic syndrome. N Engl J Med 2013; 368: 2169–81. [PubMed][CrossRef]
- 8.
Joseph A, Cointe A, Mariani Kurkdjian P et al. Shiga Toxin-Associated Hemolytic Uremic Syndrome: A Narrative Review. Toxins (Basel) 2020; 12: 67. [PubMed][CrossRef]
- 9.
Mead PS, Griffin PM. Escherichia coli O157:H7. Lancet 1998; 352: 1207–12. [PubMed][CrossRef]
- 10.
Garg AX, Suri RS, Barrowman N et al. Long-term renal prognosis of diarrhea-associated hemolytic uremic syndrome: a systematic review, meta-analysis, and meta-regression. JAMA 2003; 290: 1360–70. [PubMed][CrossRef]
- 11.
Garnier A, Brochard K, Kwon T et al. Efficacy and Safety of Eculizumab in Pediatric Patients Affected by Shiga Toxin-Related Hemolytic and Uremic Syndrome: A Randomized, Placebo-Controlled Trial. J Am Soc Nephrol 2023; 34: 1561–73. [PubMed][CrossRef]
- 12.
McFarlane PA, Bitzan M, Broome C et al. Making the Correct Diagnosis in Thrombotic Microangiopathy: A Narrative Review. Can J Kidney Health Dis 2021; 8: 20543581211008707. [PubMed][CrossRef]